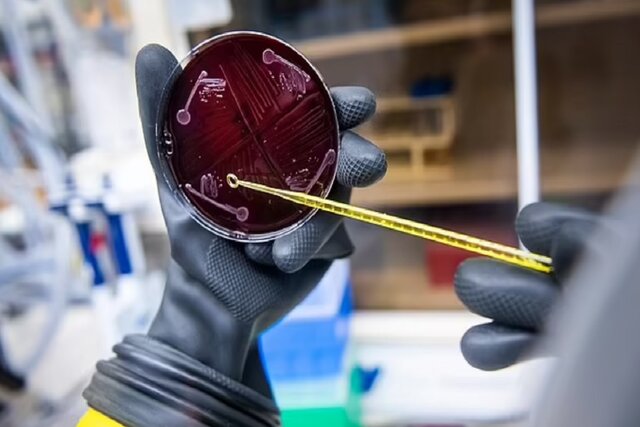
ساخت نخستین نمونه میکروبیوم انسانی در آزمایشگاه ساخت نخستین نمونه میکروبیوم انسانی در آزمایشگاه

به گزارش ایسنا و به نقل از دیلی میل، دانشمندان "دانشگاه استنفورد" (Stanford University) با موفقیت توانستند نخستین نمونه میکروبیوم انسانی را در آزمایشگاه ایجاد کنند. آنها این میکروبیوم را با ترکیب ۱۱۹ گونه باکتریایی که در بدن یافت میشوند، درست کردند و باور دارند که ممکن است به درمان عفونتهای تهدیدکننده رودهای کمک کند.
میکروبیومهای روده از صدها گونه باکتری تشکیل میشوند که در سیستم گوارش انسان زندگی میکنند و با حمایت از سیستم ایمنی و کنترل روند هضم، نقش مهمی را در سلامت انسان بر عهده دارند. هنگامی که این میکروبیوم مصنوعی به موشها پیوند زده شد، توانست تکثیر شود، از موشها در برابر باکتری "اشریشیا کلی" (E. coli) محافظت کند و یک سیستم ایمنی سالم را پدید آورد.
دانشمندان میگویند که اکنون میتوانند هر میکروب را به صورت جداگانه بررسی کنند تا نقش آنها را آشکار سازند و به پزشکان امکان دهند تا برای طراحی درمانهای مناسب، میکروبها را با هم ترکیب کنند.
حدود ۳۰ تریلیون سلول در بدن انسان وجود دارد، اما میکروبیوم انسان از حدود ۳۹ تریلیون سلول میکروبی تشکیل شده است که باکتریها، ویروسها و قارچها را شامل میشوند. میکروبیوم روده، ذخیره چربی را کنترل میکند و به فعال کردن ژنهای موجود در سلولهای انسانی میپردازد که در جذب مواد مغذی، تجزیه سموم و ایجاد رگهای خونی دخیل هستند.
همچنین این میکروارگانیسمها، پوشش داخلی روده و پوست ما را پر میکنند، به ترمیم سلولهای آسیبدیده میپردازند و سلولهای مرده را با سلولهای جدید جایگزین میکنند. آنها با میکروبهای مهاجم مبارزه میکنند و این همان چیزی است که گروه پژوهشی دانشگاه استنفورد قصد دارد آن را در پژوهش خود تجزیه و تحلیل کند.
این گروه پژوهشی در بیانیهای گفتند: بسیاری از پژوهشها در مورد میکروبیوم مهم، با استفاده از پیوند مدفوع انجام شدهاند که میکروبیوم طبیعی را از یک ارگانیسم به ارگانیسم دیگر منتقل میکند. اگرچه دانشمندان معمولا یک ژن را خاموش میکنند یا یک پروتئین را از یک سلول خاص حذف میکنند، اما چنین مجموعهای از روشها برای حذف یا اصلاح یک گونه از صدها گونه موجود در یک نمونه مدفوع وجود ندارد.

دانشمندان استنفورد تصمیم گرفتند میکروبیوم مصنوعی خود را از متداولترین باکتریها بسازند و به "پروژه میکروبیوم انسانی" (HMP) روی آوردند که ابتکار "موسسه ملی سلامت" (NIH) است. آنها با کمک این پروژه توانستند به توالییابی ژنوم میکروبی بیش از ۳۰۰ بزرگسال بپردازند.
"میشائل فیشباخ" (Michael Fischbach)، از پژوهشگران این پروژه گفت: به دنبال گونههای باکتریایی در روده انسان میگشتیم و سعی داشتیم تا گونههایی را پیدا کنیم که تقریبا همیشه در هر فردی وجود دارند.
فیشباخ و گروهش، ۱۶۶ سویه باکتریایی را که در اکثریت افراد یافت شده بودند، انتخاب کردند اما توانستند تنها ۱۰۴ گونه را به دست آورند. ۱۰۴ گونه به صورت جداگانه پرورش یافتند و سپس ترکیب شدند تا جمعیتی از ۱۱۹ سویه ایجاد شود که دانشمندان آن را "جامعه انسانی یک" (hCom1) می نامند.
این سویهها میتوانستند در آزمایشگاه رشد کنند اما دانشمندان نیاز داشتند که همین اتفاق در روده یک موجود زنده رخ دهد. آنها hCom1 را به بدن موشهایی منتقل کردند که بدون وجود باکتری طراحی شده بودند و hCom1 خود را به طور قابل توجهی پایدار نشان داد؛ به طوری که ۹۸ درصد از گونههای تشکیلدهنده، در روده این موشهای عاری از میکروب ساکن شدند و سطح فراوانی نسبی هر گونه در طول دو ماه ثابت ماند.
سپس دانشمندان، گروه جدیدی از ۱۱۹ سویه به نام "جامعه انسانی دو" (hCom2) را به به موشها دادند که باعث شد موشها در برابر مشکلات مدفوع، مقاومتر از گروه نخست باشند. دانشمندان، باکتری اشریشیا کلی را به بدن موشها انتقال دادند اما روده آنها با عفونت مبارزه کرد.
پژوهشهای پیشین نشان دادهاند که یک میکروبیوم طبیعی سالم میتواند به محافظت کمک کند اما فیشباخ و همکارانش توانستند با حذف یا اصلاح مکرر گونههای خاصی، گامی فراتر بگذارند. آنها چندین باکتری مهم را پیدا کردند و قصد دارند بررسیهای بیشتری را برای محدود کردن حیاتیترین گونهها انجام دهند.
فیشباخ معتقد است که hCom2 یا نسخههای آینده آن، پژوهشهای مشابهی را امکانپذیر میسازد که عوامل باکتریایی دخیل در حوزههای دیگر مانند واکنش نسبت به ایمنیدرمانی را نشان میدهد.
انتهای پیام